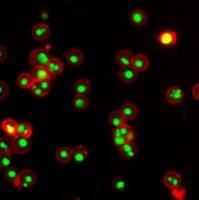
Annexin V-iFluor 555标记

相关产品推荐更多 >
万千商家帮你免费找货
0 人在求购买到急需产品
- 详细信息
- 技术资料
- 库存:
咨询
- 英文名:
FAM-xtra™ Phosphoramidite
- 保质期:
12个月
- 供应商:
西安百萤生物
- 保存条件:
在零下15度以下保存, 避免光照
- 规格:
50 umoles
FAM-xtra 亚磷酰胺基本资料
产品名称:FAM-xtra 亚磷酰胺
英文名称:FAM-xtra™ Phosphoramidite
产品货号:6037
产品规格:50 umole
品 牌:AAT Bioquest
储存条件 :在零下15度以下保存, 避免光照
保质期:12个月
FAM-xtra 亚磷酰胺产品优势
1.FAM-xtra标记的寡核苷酸具有与6-FAM标记的寡核苷酸相同的光谱。
2.FAM-xtra标记的寡核苷酸比相应的FAM-标记的寡核苷酸明亮得多。
3.FAM-xtra标记的寡核苷酸比相应的FAM-标记的寡核苷酸具有更高的光稳定性。
4.与相应的FAM标记的寡核苷酸相比,FAM-xtra标记的寡核苷酸的荧光对pH的敏感度低得多。
FAM-xtra 亚磷酰胺产品参数
Ex (nm) 493 Em (nm) 517
分子量 879.94 溶剂 MeCN
FAM-xtra 亚磷酰胺产品概述
6-FAM已广泛用于各种qPCR探针,但其荧光存在高度依赖pH值和快速光漂白2个局限性,用于标记5'端的寡核苷酸。AAT Bioquest生产的FAM-xtra 亚磷酰胺解决了这个局限性的同时,保留了6-FAM亚磷酰胺的操作便利性。 在相同条件下,FAM-xtra亚磷酰胺和6-FAM亚磷酰胺使用方法一样。百萤生物是AAT Bioquest的中国代理商,为您提供FAM-xtra 亚磷酰胺。
风险提示:丁香通仅作为第三方平台,为商家信息发布提供平台空间。用户咨询产品时请注意保护个人信息及财产安全,合理判断,谨慎选购商品,商家和用户对交易行为负责。对于医疗器械类产品,请先查证核实企业经营资质和医疗器械产品注册证情况。
技术资料暂无技术资料 索取技术资料